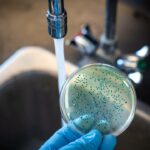

El Consejo Nacional Electoral (CNE) resolvió este miércoles 12 de julio de 2023 ampliar en más de un mes la campaña electoral para los comicios presidenciales extraordinarios del próximo 20 de agosto, cuyo periodo se extenderá del 13 de julio al 17 de agosto.
En un primer momento, el CNE había fijado un periodo de campaña entre el 8 y el 17 de agosto, pero por pedido de los grupos políticos inmersos en el proceso y para propiciar un mayor conocimiento de los ciudadanos de los planes de gobierno de los postulantes, el pleno del organismo resolvió ampliar dicho plazo.
Con tres votos a favor y dos abstenciones, el pleno del CNE actualizó el «Calendario Electoral y el Plan Operativo de las Elecciones Anticipadas» y amplió a 36 días el periodo de la campaña, que en principio era de apenas nueve jornadas.
La decisión obedeció también a que el Tribunal Contencioso Electoral (TCE) certificó la inscripción de los ocho candidatos presidenciales.
El CNE aclaró que la campaña electoral para designar a los integrantes de la Asamblea Nacional (Parlamento) se mantendrá entre el 8 y el 17 de agosto.
Los próximos comicios presidenciales y legislativos responden a una decisión del actual mandatario, el conservador Guillermo Lasso, que en mayo pasado invocó el mecanismo constitucional conocido como «muerte cruzada», por el cual disolvió la Asamblea Nacional (Parlamento), recortó su periodo y convocó a elecciones anticipadas.
El ganador de los comicios presidenciales del 20 de agosto completará el periodo 2021-2025 que le correspondía a Lasso, pero que fue recortado por el gobernante en un momento en que el Parlamento, de mayoría opositora, se disponía a debatir y votar su destitución en un juicio político en el que era acusado de peculado (malversación), algo que él rechaza.
La autoridad electoral ya ha calificado las candidaturas presidenciales del izquierdista y ambientalista Yaku Pérez, de la exlegisladora Luisa González (del movimiento Revolución Ciudadana que lidera el expresidente Rafael Correa) y del exvicepresidente Otto Sonnenholzner.
También del especialista en seguridad Jan Topic, el periodista y exlegislador Fernando Villavicencio, el empresario Xavier Hervas, el exlegislador Daniel Noboa (hijo del magnate bananero Álvaro Noboa) y el abogado independiente Bolívar Armijos. EFE